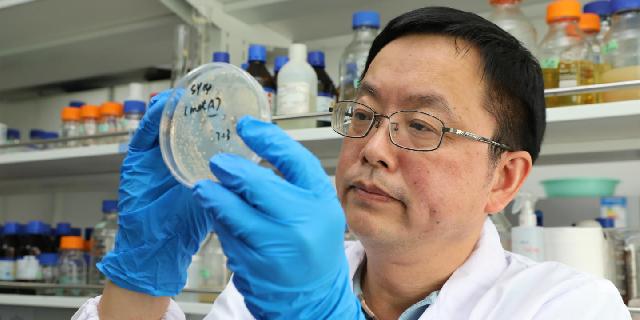

人类能否创造生命?这个看似天马行空的想法,却是科学界孜孜以求的重大课题。
不久前,中国科学院分子植物科学卓越创新中心/植物生理生态研究所的覃重军研究团队与合作者创建了仅含单条染色体的真核细胞,打破了“真核生物通常含有多条染色体”这一自然界限,向世界宣告:中国科学家独立创造了全新的自然界不存在的生命。
创建“人造生命”,突破自然界限
评价一位科学家有多“牛”,可以参考他发表的论文。然而近5年来,覃重军的论文数量并不弹眼落睛,平均每年发表的论文还不到1篇。每天,他不是关在实验室里闷头捣鼓,就是在单位的院子里散步琢磨事儿。
覃重军工作的中科院植物生理生态研究所(摄影 何雅君)
然而,他所在的中国科学院分子植物科学卓越创新中心/植物生理生态研究所态度十分“宽容”,非但没冷落他,还让他当了中科院合成生物学重点实验室主任。因为他们知道,覃重军琢磨的事儿,从来没有人做过,比如,人类能否创造生命?
2018年8月2日,国际顶级期刊《自然》(Nature)杂志在线发表了一篇论文,覃重军研究团队与合作者在国际上首次人工创建了仅含单条染色体的真核细胞,打破了真核生物通常含有多条染色体这一自然界限。它被称为“人造生命”,是合成生物学领域具有里程碑意义的重大突破。一位法国遗传学家说:“令人惊讶的是,这些细胞实际可以存活。”
覃重军积累了两千多页课题实验手稿
覃重军团队的这项研究成果,获得了2018年度“中国科学十大进展”,将可能进一步加强人类对生命过程的调节和控制能力的探索。这种单染色体酵母的诞生,被认为是继上世纪60年代中国人工合成牛胰岛素和tRNA(具有携带并转运氨基酸功能的一类小分子核糖核酸)之后,中国在合成生物学领域的又一个重要贡献。
覃重军研究团队讨论实验进展
它也更像是一个新的范例:覃重军和他的同事将经典分子生物学的“假设驱动”与合成生物学的“工程化研究模式”相结合,为学科的发展提供了新的思路。
科学家的目标是开创未来,造福人类
覃重军能带领团队,在科研工作中取得如此重大的突破,和他“脑洞够大”有关。他认为,思想是人最强大的力量,每次开展一个新的研究,都是他实现思想超越的过程。
覃重军的实验思路笔记
面对不断变化的时代,他一直在拓展着自己的研究方向,探索着什么是真正热爱的,什么是真正有价值的,什么是能够解决人类普遍问题的。“所有的伟人都有一个共性,如果是自己真正热爱的,一定会顽强做下去,不会受到外界的干扰。”
喜欢学习伟人,是覃重军的习惯。1983年,这个18岁的湖南青年考取了武汉大学生物系微生物专业。在探索自然科学世界的同时,他也痴迷于哲学,试图验证一种假设:任何普通人都能成功。
1983年,覃重军考取了武汉大学(供图 覃重军)
他早就发现,按部就班地前行并不适合他。论课业成绩,他并不出众。但在华中农业大学攻读研究生时,他已经利用实验课上的研究成果,与人合作发表了论文。
一个科学家的成就,难道只是多发几篇论文吗?博士毕业后,覃重军陷入了沉思,想起了自己的偶像、近代微生物学奠基人巴斯德。巴斯德不仅是个理论上的天才,更是个善于解决实际问题的人,在战胜狂犬病、鸡霍乱、炭疽病、蚕病等方面都取得了成果。
覃重军决定,向偶像学习,为人生做出最好的选择。他向美国斯坦福大学寄出了做博士后申请,很快收到回复,前往这座心中的学术殿堂接受科学研究的正规化训练。
回国后,他选择到中国科学院植物生理生态研究所工作,投身产学研结合的道路。他喜欢这里的文化氛围和传统,认为这个环境可以让他继续验证自己的成功假设,安静地追求更大的理想。
覃重军研究员指导学生做实验
他告诉学生,开创未来是当代科学家们的努力方向之一,应用更是微生物研究的最终归宿。解决人类疾病问题是科学的最终目标之一,远比发表文章更让人欣慰,对人类更有价值。